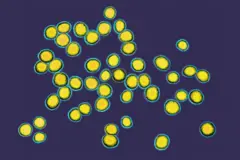
Staphylococcus aureus no microscópio

Crédito, Getty Images
- Author, Jasmin Fox-Skelly
- Role, BBC Future
Se você arranhar a superfície da pele, vai encontrar uma comunidade de bactérias vivendo nela. Isso é uma coisa boa, à medida que as pesquisas mostram cada vez mais que ter o “tipo certo” de micróbios pode ajudar a manter nossa pele jovem, macia e suave por mais tempo.
Simplesmente por estarem presentes, as “bactérias boas” nos protegem de infecções causadas por micróbios patogênicos e prejudiciais. Elas também ajudam a cicatrizar feridas, e podem até mesmo neutralizar alguns dos efeitos nocivos dos raios UV.
Mais um motivo para cuidarmos do microbioma da nossa pele. Mas como podemos fazer isso? Um método que tem se tornado cada vez mais popular é o uso de probióticos tópicos para a pele — o que tecnicamente significa aplicar microrganismos vivos na pele para melhorar sua saúde.
Já em 1912, cientistas esfregavam bactérias no rosto das pessoas na tentativa de melhorar condições como acne e seborreia — uma forma comum de dermatite que causa uma erupção cutânea vermelha, com coceira, além de escamas brancas ou amareladas.
Atualmente, há dezenas de empresas de cuidados com a pele que vendem o que descrevem como produtos probióticos, de séruns a produtos para limpeza e hidratantes. Em todos os casos, os bálsamos oferecem o reequilíbrio do delicado microbioma da pele, deixando-a “renovada” e “revigorada”.
No entanto, embora os produtos de cuidados com a pele frequentemente afirmem ser “probióticos”, muito poucos ou praticamente nenhum deles realmente contêm bactérias vivas.
Além disso, como os tratamentos probióticos para a pele são classificados como “cosméticos” — e não como medicamentos, seus fabricantes não precisam compartilhar os resultados dos testes realizados com seus produtos. Por isso, é difícil saber quão eficazes eles são.
“As regras relativas a produtos para cuidados com a pele são muito diferentes das regras relativas a medicamentos. Portanto, as alegações podem ser feitas com base em testes menos rigorosos do que seriam feitos para um agente farmacêutico”, explica Richard Gallo, dermatologista da Faculdade de Medicina da Universidade da Califórnia em San Diego, nos EUA.
A maioria dos produtos “probióticos” para cuidados com a pele contém prebióticos — nutrientes que alimentam e estimulam o crescimento de bactérias boas na pele — ou posbióticos — proteínas ou outros produtos produzidos por bactérias benéficas.
“O que estamos vendo cada vez mais são abordagens que tentam influenciar o microbioma”, diz Bernhard Paetzold, cofundador e diretor científico da S-Biomedic, empresa que tem como objetivo tratar condições restaurando o microbioma da pele por meio de “transplantes” bacterianos.
De acordo com Paetzold, a principal razão para isso é que é extremamente difícil manter as bactérias vivas durante todo o processo de fabricação, armazenamento e distribuição. Uma vez na pele, não há garantias de que elas vão se fixar, pois precisam lutar para competir com os milhões de outros micróbios que já vivem lá.

Crédito, Getty Images
A ideia de promover um microbioma saudável para a pele está enraizada na teoria de que as bactérias e os fungos que vivem na parte externa do nosso corpo ajudam a nos proteger daqueles que podem nos prejudicar.
No entanto, a ciência por trás de como certas bactérias “nocivas” podem contribuir para doenças de pele ainda não é totalmente compreendida. O que sabemos é que pessoas com eczema, rosácea, acne e psoríase têm diferentes tipos ou níveis de determinadas bactérias vivendo em sua pele.
“O que existe no momento são muitos artigos mostrando que quase todas as doenças de pele imagináveis estão associadas a uma mudança no microbioma da pele”, diz Paetzold. “Mas esta observação mostra apenas uma associação. Ela não diz que a mudança no microbioma causa a doença. Também pode ser que a doença mude o ambiente da pele, e é por isso que a população bacteriana muda.”
Para provar que uma determinada cepa de bactéria está causando uma doença, você precisaria causar a doença de pele em uma pessoa saudável, aplicando as “bactérias nocivas” no rosto, ou curar a doença aplicando bactérias “boas”. Enquanto a primeira opção provavelmente esbarra em barreiras éticas, alguns pesquisadores estão tentando a segunda.
Os poucos ensaios clínicos publicados mostram, no entanto, resultados promissores. A maioria se concentra no uso de bactérias vivas para tratar eczema, condição também conhecida como dermatite atópica. Eles se baseiam nas descobertas de que a pele de pessoas com eczema é dominada por Staphylococcus aureus, uma bactéria que muitas vezes pode ser patogênica.
“Um dos grandes problemas da pele em doenças como eczema é que certas bactérias patogênicas, como a S. aureus, vivem na superfície da pele e causam erupções cutâneas, doenças e infecções”, diz Gallo, cujo grupo de pesquisa tem procurado maneiras de aproveitar o microbioma da pele para combater as bactérias nocivas que prosperam em pacientes com eczema.
“Nós exploramos os tipos de bactérias que normalmente vivem na pele saudável, procurando bactérias que possam produzir coisas que combatam essas bactérias ruins”.
A equipe de Gallo está se concentrando na Staphylococcus hominis, uma bactéria natural da pele que está presente em 21% das pessoas saudáveis, mas em apenas 1% dos pacientes com dermatite atópica.
“Nossa pele oferece às bactérias comensais, como a S. hominis, um local seguro para viver, de modo que algumas delas desenvolveram uma maneira de proteger seu ambiente destas bactérias nocivas que estão tentando invadir”, explica Gallo.
No caso da S. hominis, a bactéria produz peptídeos antimicrobianos — pequenos fragmentos de proteína — que matam diretamente a S. aureus. Ela também produz substâncias químicas chamadas “peptídeos autoindutores”, que impedem que as células bacterianas se comuniquem umas com as outras.
Algumas bactérias, como a S. aureus, sinalizam umas para as outras quando sua densidade populacional atinge um determinado nível — um mecanismo conhecido como quorum sensing (sensor de quórum) — desencadeando a secreção de toxinas que podem causar inflamação na pele. Interromper esta comunicação pode impedir que as toxinas sejam liberadas.
Em 2021, a equipe de Gallo conduziu um estudo controlado randomizado de fase um com 54 adultos com dermatite atópica, aplicando um creme contendo S. hominis viva ao longo de uma semana. Os resultados mostraram que o tratamento com S. hominis reduziu drasticamente a colonização por S. aureus — e diminuiu até mesmo a vermelhidão e a coceira associadas à dermatite atópica em um subgrupo de pacientes, em comparação com um grupo de controle que recebeu um creme placebo.
As descobertas sugerem que o uso de fórmulas especiais de bactérias vivas poderia muito bem ajudar a tornar o microbioma da pele mais saudável. Mas é preciso pesquisar mais para comprovar sua eficácia antes que possa ser usado como tratamento.
A equipe está agora recrutando para um estudo randomizado de fase dois que vai avaliar a eficácia do tratamento em um período mais longo, de 14 semanas.
Em outros lugares, outros pesquisadores também tiveram sucesso no tratamento de eczema com probióticos. Em um ensaio clínico de 2003, 11 pacientes com dermatite atópica receberam um creme contendo a bactéria Streptococcus thermophiles, que eles aplicaram por duas semanas. Os resultados mostraram que o creme aumentou a produção de ceramidas na pele — lipídios que ajudam a manter a pele hidratada e como uma barreira saudável.
Mais recentemente, em 2018, 10 adultos e cinco crianças com dermatite atópica foram submetidos a um “transplante de microbioma”, no qual a bactéria viva Roseomonas mucosa coletada da pele de voluntários saudáveis foi aplicada na pele dos pacientes duas vezes por semana. Após 16 semanas, o tratamento melhorou seus sintomas em mais de 50%.
Crédito, Getty Images
Embora os ensaios clínicos com foco em outras doenças de pele sejam um pouco mais raros, eles também apresentam resultados promissores. A acne, por exemplo, está ligada à colonização pela bactéria Cutibacterium acnes. Alguns pesquisadores estão procurando, portanto, bactérias que produzam peptídeos antimicrobianos para inibir ou matar esta bactéria.
Em um estudo clínico, uma loção contendo a bactéria Enterococcus faecalis foi aplicada em pacientes que sofriam de acne grave. A loção reduziu significativamente as pústulas, em comparação com uma loção placebo.
Em paralelo, Paetzold e sua empresa S-Biomedic publicaram um ensaio clínico em 2019, no qual deram a pacientes com acne um creme contendo cepas específicas de Cutibacterium acnes. Os resultados mostraram alguma redução na acne.
Gallo também está pesquisando se uma cepa da bactéria Staphylococcus capitis poderia ser um tratamento eficaz para a acne, com estudos em animais mostrando resultados promissores.
“O mecanismo básico de ação é muito simples. Ele simplesmente inibe o crescimento da C. acnes, da mesma forma que os antibióticos tópicos ou antibióticos orais são usados para tratar a acne”, explica Gallo.
No entanto, diferentemente dos antibióticos tópicos, o tratamento visa especificamente a C. acnes, de modo que o microbioma mais amplo da pele não é afetado, segundo ele.
A equipe de Gallo encontrou até mesmo uma cepa específica da bactéria Staphylococcus epidermidis que produz moléculas que podem inibir o desenvolvimento do câncer de pele induzido pelo Sol.
“Ela gera uma pequena molécula que inibe a síntese de DNA em células da pele transformadas ou mutagênicas”, diz Gallo.
“Descobrimos em modelos animais que, se estas bactérias estiverem presentes na superfície de camundongos que sofreram danos causados pela radiação UV, eles desenvolvem muito menos tumores de pele do que os camundongos que têm a mesma espécie de bactéria, mas não os genes [das bactérias] que produzem esse antimetabólito.”
É claro que tal tratamento vai ter que passar por muito mais testes e ensaios clínicos antes que seja possível demonstrar que tem um efeito semelhante em seres humanos.

Crédito, Getty Images
Embora a maioria dos estudos tenha analisado o tratamento de doenças específicas com probióticos, há também alguns que examinaram se os prebióticos ou posbióticos poderiam melhorar a saúde da pele em geral.
Por exemplo, alguns pesquisadores estão analisando se a inulina — uma fibra alimentar frequentemente encontrada em cosméticos e produtos de cuidados pessoais — poderia servir como prebiótico quando tomada como suplemento oral ou aplicada topicamente na pele.
Os resultados preliminares sugerem que a inulina torna a pele mais suave e macia, proporcionando um ambiente mais favorável para o desenvolvimento de bactérias benéficas.
Outros estudos demonstraram que a aplicação de esfingomielinase, uma enzima produzida por bactérias como a Staphylococcus thermophilus — comumente encontrada em produtos lácteos fermentados e iogurte — pode aumentar a produção de ceramidas, que são necessárias para manter a pele saudável.
No entanto, em todos os casos, são necessários grandes estudos clínicos do tipo duplo-cego randomizado — o padrão ouro da pesquisa médica — para confirmar se algum desses cremes é eficaz.
Por exemplo, um estudo de revisão recente analisou todos os dados de ensaios clínicos realizados até o momento, e concluiu que, embora “os probióticos orais e tópicos pareçam ser eficazes para o tratamento de determinadas doenças inflamatórias da pele, e demonstrem um papel promissor na cicatrização de feridas e no câncer de pele, são necessários mais estudos para confirmar estes resultados”.
Gallo concorda que mais pesquisas são necessárias, mas está otimista em relação ao futuro deste campo de estudo.
“Está avançando na direção certa”, diz ele. “Percebemos, como campo, que precisamos entender o que exatamente eles estão fazendo, e há muitos esforços sendo feitos nesse sentido, assim como outras maneiras de desenvolver micróbios para nos beneficiar. Portanto, estou muito otimista em relação a onde vamos estar em alguns anos com os probióticos.”
No entanto, para as pessoas que não têm uma doença de pele, mas que talvez queiram aumentar a suavidade da pele, prevenir rugas ou aumentar os níveis de hidratação, há poucas evidências de que os cremes probióticos à venda ofereçam algum benefício.
“Acho que muitos dos probióticos disponíveis no mercado atualmente não têm evidências muito fortes por trás deles. Então, eu não os recomendaria necessariamente”, diz Gallo.
“Você pode experimentá-los — mas talvez não seja o melhor uso do seu dinheiro.”
Embora o microbioma da pele mude à medida que você envelhece e se depara com diferentes ambientes, há algumas coisas que você pode fazer para ajudar o microbioma natural da sua pele a prosperar.
“É uma via de mão dupla, porque os tipos de coisas que já estamos fazendo para hidratar nossa pele ou proteger a pele dos danos causados pelos raios UV estão criando um ambiente mais hospitaleiro para esses organismos benéficos viverem”, explica Gallo.
“Então, são os cuidados normais com a pele, a hidratação e a limpeza adequadas — todas essas coisas vão promover a saúde da pele.”
Fonte.:BBC NEWS BRASIL


